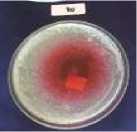
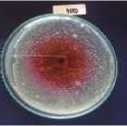

KANDUNGAN SENYAWA FLAVONOID DAN ANTOSIANIN EKSTRAK KAYU SECANG (Caesalpinia sappan L.) SERTA AKTIVITAS ANTIBAKTERI TERHADAP Vibrio cholerae
on
ISSN : 2527-8010 (ejournal)
Jurnal Ilmu dan Teknologi Pangan Vol. 8, No. 2, 216-225, Juni 2019
KANDUNGAN SENYAWA FLAVONOID DAN ANTOSIANIN EKSTRAK KAYU SECANG (Caesalpinia sappan L.) SERTA AKTIVITAS ANTIBAKTERI TERHADAP Vibrio cholerae
Flavonoid and Anthocyanin Analysis of Sappan Wood Extract (Caesalpinia sappan L.) and Antibacterial Activity Against Vibrio cholerae
Ni Made Gress Rakasari Nomer1), Agus Selamet Duniaji 2), Komang Ayu Nocianitri2) 1)Mahasiswa Program Studi Imu dan Teknologi Pangan, Fakultas Teknologi Pertanian, Unud 2)Dosen Program Studi Imu dan Teknologi Pangan, Fakultas Teknologi Pertanian, Unud Kampus Bukit Jimbaran, Badung-Bali
ABSTRACT
The aim of this research to determine the concentration of flavonoid and anthocyanin compounds in sappan wood extract (Caesalpinia sappan L.), as well as to determine the concentration of inhibitory power against the growth of Vibrio cholerae. This experimental design study uses 5 kind of concentration, which are 20%, 40%, 60%, 80%, 100%. The analysis were repeated 3 times and resulting in 15 experimental units. The data were presented in descriptive statistic with tables, drawings and discussed. The results showed that the extract of sappan wood contained flavonoid compounds of 6,02%, anthocyanin compounds of 2,43% and was able to inhibit the growth of Vibrio cholerae with optimal concentration at a concentration of 80% with an average 20,1 mm and very strong inhibition categories.
Keywords: flavonoid, anthocyanin, sappan wood, antibacterial, Vibrio cholerae.
PENDAHULUAN
Indonesia memiliki berbagai jenis tumbuhan yang dapat dimanfaatkan sebagai bahan baku obat-obatan, diantaranya obat tradisional, minuman herbal atau jamu. Salah satu tanaman yang dimanfaatkan oleh sebagian masyarakat sebagai minuman yang memiliki khasiat adalah kayu secang (Caesalpinia sappan L.). Kayu secang merupakan bagian batang dari tanaman secang yang kayunya mengandung senyawa-senyawa metabolit sekunder. Selain itu, tanaman secang digunakan sebagai salah satu pigmen alami karena menghasilkan pigmen berwarna merah.
Tanaman kayu secang memiliki kandungan kimia flavonoid, brazilin, alkaloid, saponin,
tanin, fenil propane, dan terpenoid (Sudarsono et al., 2002). Panovska et al., 2005 melaporkan bahwa kayu secang mengandung senyawa fenolik seperti flavonoid, yang mempunyai aktivitas antioksidan penangkap radikal bebas. Golongan flavonoid yang ada pada kayu secang salah satunya yaitu antosianin. Senyawa antosianin adalah bentuk glikosida dari senyawa antosianidin dan merupakan bagian dari metabolit sekunder flavonoid. Antosianin merupakan senyawa yang baik untuk kesehatan karena memiliki aktivitas antioksidan (Abdel-Aal et al., 2006), antibakteri, antiinflamasi, antikanker, lipid peroxidation (Lefevre et al., 2004).
Tingginya kandungan antioksidan dan senyawa metabolit pada kayu secang meningkatkan pemanfaatan minuman yang
*Korespondensi Penulis:
Email: nimadegressr@yahoo.com 1)
berasal dari tumbuhan sebagai alternatif antidiare dan antibakteri. Diare sebagaian besar disebabkan karena adanya infeksi pada saluran pencernaan oleh adanya bakteri, diantaranya adalah bakteri Vibrio cholerae, Staphylococcus aureus dan E. coli. Hasil penelitian Dianasari (2009) menunjukkan bahwa ekstrak etanol kayu secang memiliki aktivitas antibakteri terhadap Staphylococcus aureus dan Shigella dysentriae serta ekstraksi dengan metanol pada kayu secang juga memiliki daya antibakteri terhadap Staphylococcus aureus dan E. coli (Sumarni, 1994).
Vibrio cholerae adalah bakteri gram negatif berbentuk basil (batang) bengkok, bersifat aerob dan motil, serta mempunyai satu flagel kutub. Vibrio cholerae merupakan salah satu mikroba penyebab penyakit yang sering ditemukan pada bahan pangan, biasanya Vibrio cholerae mencemari makanan yang bersumber dari laut seperti kerang-kerangan maupun ikan karena adanya kontaminasi pada air laut. Bila bakteri ini mencemari makanan dan terkonsumsi dalam jumlah tertentu, maka dapat menyebabkan penyakit kolera. Vibrio cholerae masuk ke dalam tubuh seseorang melalui makanan dan minuman yang telah terkontaminasi oleh bakteri tersebut, kemudian Vibrio Cholerae mengeluarkan enterotoksin di dalam tubuh seseorang pada bagian saluran usus, sehingga menimbulkan diare disertai muntah yang akut dan sangat hebat, dan berakibat seseorang dalam waktu hanya beberapa hari akan kehilangan banyak cairan dalam tubuhnya sehngga mengalami dehidrasi.
Berdasarkan data diatas maka penelitian ini dilakukan untuk mengetahui kandungan senyawa flavonoid dan antosianin yang dimiliki oleh kayu secang dan menguji adanya aktivitas antibakteri ekstrak etanol kayu secang terhadap Vibrio cholerae dengan metode difusi sumur.
METODE PENELITIAN
Bahan dan Alat
Bahan yang digunakan dalam penelitian ini adalah kayu secang yang diperoleh dari desa Sakti, Kecamatan Nusa Penida, Kabupaten Klungkung, bakteri Vibrio Cholerae yang diperoleh dari Bali Seafood Inspection Laboratory, Sanur, Bali, etanol 96%, aquades, TCBS (Thiosulfate Citrate Bile Salts Sucrose) , LB (Lactose Broth), NA (Nutrient Agar), PW (Peptone Water), alkohol 95%, NaNO2, AlCl3, NaOH, metanol, HCl, KCl.
Alat yang digunakan dalam penelitian ini adalah blender, evaporator, water bath, spektrofotometer UV Vis, autoklaf, batang bengkok, timbangan analitik, mikropipet, freezer, inkubator (Memmert), tip, laminar flow cabinet (Kojair), bunsen, magnetic stirrer, tabung durham, kertas label, vortex, korek api, mikroskop, cawan petri (Pyrex), jarum ose, tabung reaksi (Pyrex), gelas beker (Pyrex), erlenmeyer (Pyrex), gelas ukur (Pyrex), jangka sorong dan tabung effendorf, tissue, plastik HDPE, kertas saring, aluminium foil (Klin Park), plastik HDPE.
Pelaksanaan Penelitian
Persiapan ekstrak kayu secang
Ekstraksi kayu secang dilakukan dengan metode maserasi. Sebanyak 100 gram serbuk kayu secang dimaserasi dalam 1000 ml etanol 96% (1:10) selama 3x24 jam dalam suhu kamar dan dilakukan pengadukan 24 jam sekali. Kemudian maserat disaring untuk memisahkan ampas dan filtratnya lalu dievaporasi menggunakan rotary evaporator pada suhu 40°C hingga ekstrak mengental. Ekstrak kental yang diperoleh ditimbang dan disimpan di dalam desikator sebelum digunakan untuk uji selanjutnya (Selawa et al., 2013 yang dimodifikasi).
Penyegaran Bakteri
Penyegaran kultur dilakukan dengan cara diinokulasi 1 ose biakan isolate Vibrio
cholerae dalam media NA kedalam tabung reaksi yang berisi 5 ml medium LB steril. Setelah itu inokulum diinkubasi dalam inkubator selama 18-24 jam pada suhu 370C. Pertumbuhan Vibrio cholerae dapat dilihat dengan adanya kekeruhan pada media LB.
Uji Konfirmasi Vibrio cholerae
Pada uji konfirmasi ini dengan pengamatan bentuk koloni, pewarnaan gram dan pengamatan bentuk sel. Isolat bakteri yang sudah disegarkan kemudian dibiakan pada media TCBS dengan cara digoreskan agar diperoleh koloni tunggal dan diinkubasi selama 48 jam dengan suhu 37oC. Diamati bentuk dan warna koloni bakteri. Pewarnaan gram dilakukan dengan isolat bakteri yang telah disegarkan diratakan pada kaca objek yang sudah dibersihkan dan difiksasi ± 20 cm diatas api bunsen. Preparat ditetesi dengan pewarna Kristal violet yang didiamkan selama ± 1 menit, kemudian dibilas dengan air mengalir dengan posisi preparat dimiringkan dan larutan lugol kemudian didiamkan selama 1 menit dan kembali dibilas serta dikeringkan. Preparat kembali ditetesi dengan etanol 95% dan didiamkan selama ± 30 detik dan kembali dibilas serta dikeringkan. Terakhir, preparat ditetesi dengan safranin dan didiamkan selama 10 - 20 detik, kemudian dibilas dan dikeringkan seperti hal sebelumnya, lalu preparat diamati dibawah mikroskop dengan pembesaran 1000 kali.
Pembuatan Stok Kultur (Vibrio cholerae)
Untuk pembuatan stok kultur bakteri diambil satu koloni bakteri Vibrio cholerae dengan menggunakan jarum ose, lalu ditanamkan pada media Nutrien Agar miring dengan cara menggores, setelah itu diinkubasi dalam inkubator pada suhu 37°C selama 24 jam.
Variabel yang Diamati
Variabel yang diamati adalah kadar flavonoid (Xu and Chang, 2007), kadar
antosianin (Nollet, 2004), dan aktivitas antibakteri terhadap Vibrio cholerae dengan metode sumuran (Misna and Khusnul, 2016).
HASIL DAN PEMBAHASAN
Uji Kuantitatif Flavonoid dan Antosianin
Pengujian senyawa flavonoid dan antosianin ekstrak kayu secang dilakukan secara kuantitatif. Menurut Widowati, 2011 secara kualitatif ekstrak kayu secang positif mengandung senyawa fitokimia flavonoid. Hasil pengujian kadar senyawa flavonoid dan antosianin ekstrak kayu secang dapat dilihat pada Tabel 1.
Tabel 1. Rata-Rata Total Senyawa Flavonoid | |
dan Antosianin Ekstrak Kayu | |
Secang | |
Senyawa Fitokimia |
Hasil Rataan (%) |
Flavonoid |
6,02% ± 0,6 |
Antosianin |
2,43% ± 0,5 |
Berdasarkan Tabel 1 dapat dilihat bahwa kadar senyawa flavonoid yang didapat pada ekstrak kayu secang sebesar 6,02% dengan menggunakan pelarut etanol. Pengujian flavonoid dilakukan tanpa perlakuan dimana hanya pengujian bahan ekstrak kayu secang dengan tiga kali pengulangan penghitungan. Pada penelitian Rusita dan Suhartono (2016) didapatkan total flavonoid ekstrak kayu secang sebesar 0,19% dengan pelarut air, sedangkan Kimestri et al., (2018) didapatkan total flavonoid sebesar 0,184% dengan pelarut air. Perbedaan hasil yang didapat bisa karena beberapa faktor, salah satunya pelarut yang digunakan. Menurut Sudarmadji et al., (1997) efektivitas ekstraksi dipengaruhi oleh tingkat kelarutan bahan dengan pelarut yang digunakan.
Etanol merupakan salah satu pelarut yang bersifat polar, menurut Moein and Mahmood (2010), pelarut yang bersifat polar mampu melarutkan fenol lebih baik, dimana turunan fenol tertinggi adalah flavonoid. Kemungkinan tingkat kepolaran flavonoid
dengan kepolaran etanol sama. Pada umumnya pelarut yang banyak digunakan adalah etanol karena etanol mempunyai polaritas yang tinggi sehingga dapat mengekstrak bahan lebih banyak dibandingkan jenis pelarut lain. Sejalan dengan pendapat Sudarmadji, 2003 bahwa etanol dapat mengekstrak senyawa aktif yang lebih banyak dibandingkan jenis pelarut organik lainnya.
Faktor lain yang mempengaruhi perbedaan hasil yang didapat yaitu metode yang dilakukan berbeda, pada penelitian ini hanya dilakukan proses ekstraksi maserasi pada suhu ruang sedangkan pada penelitian total flavonoid ekstrak kayu secang Rusita dan Suhartono, (2016) menggunakan proses pemanasan suhu 90oC dan Kimestri et al., (2018) dilakukan proses pemanasan hingga suhu 100oc pada ekstraksi. Menurut Koirewoa, 2012 golongan senyawa flavonoid tidak tahan panas, selain itu senyawa flavonoid mudah teroksidasi pada suhu yang tinggi. Hal ini mengakibatkan total flavonoid yang didapat lebih kecil.
Tabel 1 menunjukkan bahwa ekstrak kayu secang mengandung senyawa antosianin sebesar 2,43%. Antosianin adalah turunan dari senyawa metabolit sekunder flavonoid yang berfungsi sebagai antioksidan. Antosianin juga merupakan pigmen yang bertanggung jawab pada warna merah, ungu, orange dan biru. Kayu secang menghasilkan pigmen berwarna merah dan pigmen merah ini disebut antosianin (Karlina et al., 2016). Sedangkan pada bahan lain, ekstrak rosella (Hibiscus Sabdariffa L.) yang juga memiliki pigmen merah, memiliki kandungan antosianin sebesar 0,11% dengan pelarut etanol dan metode maserasi (Suzery et al., 2010).
Perbedaan total senyawa fitokimia pada tanaman disebabkan karena adanya beberapa faktor, diantaranya seperti perbedaan komponen aktif pada tanaman, efek sinergis ataupun efek antagonis, kondisi penelitian,
dan metode yang digunakan seperti lama maserasi ataupun pelarut. Selain itu, menurut Bermawie et al., 2008 perbedaan hasil jumlah kandungan zat yang terbentuk pada tanaman dapat dipengaruhi oleh beberapa faktor diantaranya seperti faktor lingkungan dan geografis, seperti adanya iklim, intensitas cahaya, suhu, kesuburan tanan, kelembapan, curah hujan, serta ada tidaknya hama dan penyakit.
Uji Konfirmasi Vibrio cholerae
Pengujian konfirmasi pada Vibrio cholerae meliputi warna dan bentuk koloni serta pewarnaan gram dan bentuk sel. Vibrio cholerae tumbuh baik pada media agar TCBS. Pada warna koloni Vibrio cholerae akan mengubah media selektif TCBS yang berwarna hijau menjadi warna kuning. Hal ini sesuai dengan Widyastana, (2015) bahwa pada sampel yang positif tercemar Vibrio cholerae menunjukkan hasil koloni berwarna kuning pada media TCBS Agar. Perubahan warna pada media TCBS disebabkan karena bakteri tersebut memfermentasi sukrosa dan menurunkan pH media sehingga menjadi asam. Sedangkan pada bentuk koloni Vibrio cholerae dihasilkan bentuk bulat dengan permukaan yang halus. Menurut Khariri, 2013 Vibrio cholerae memiliki morfologi koloni yang besar dengan diameter < 3 mm, permukaan yang halus, agak datar, bagian tengah buram dan bagian pinggir terang, berwarna kuning. Pengamatan warna dan bentuk koloni dapat dilihat pada Gambar 1.
Gambar 1. Bentuk dan warna koloni Vibrio cholerae pada TCBS
Pada pewarnaan gram menunjukkan pembentukkan warna menjadi warna merah setelah ditetesi safranin. Reaksi perubahan warna pada bakteri didasarkan atas perbedaan komposisi kimiawi dinding sel. Bakteri Gram negatif akan menyerap safranin dan menggunakannya sebagai warna bakteri. Hal ini karena bakteri gram negatif memiliki peptidoglikan yang lebih tipis daripada bakteri gram positif (Sunatmo, 2007). Karena dinding sel bakteri gram negatif tersusun atas lipid yang tebal, saat diteteskan alkohol lapisan lipid akan larut sehingga pori–pori dinding selnya akan terbuka lebar dan warna ungu kristal violet akan keluar selanjutnya pada pemberian safranin dinding sel bakteri gram negatif menyerap warna merah pada safranin. Hal ini sesuai dengan Karmana (2008) yang menyatakan bahwa karena telah kehilangan warna ungu, bakteri Gram negatif akan berikatan dengan safranin dan berwarna merah.
Bentuk sel pada Vibrio cholerae menunjukkan bentuk basil (batang) pendek yang agak bengkok. Menurut Amelia, (2005) Vibrio cholearae merupakan bakteri gram negatif dengan ukuran panjang 2-4 µm dan berbentuk batang bengkok seperti koma. Hasil pengamatan pewarnaan gram dan bentuk sel Vibrio cholerae dengan menggunakan mikroskop dapat dilihat pada Gambar 2.
Gambar 2. Morfologi Vibrio cholerae dengan mikroskop pada pembesaran 1000x.
Aktivitas Antibakteri Ekstrak Kayu Secang (Caesalpinia sappan L.) Terhadap
Pertumbuhan Vibrio cholerae
Berdasarkan penelitian yang telah dilakukan ekstrak kayu secang mampu menghambat pertumbuhan Vibrio cholerae. Uji aktivitas antibakteri terhadap Vibrio cholerae dilakukan dengan metode difusi sumur dengan menggunakan media NA. Metode difusi sumur dinilai lebih efektif dilakukan untuk uji aktivitas antibakteri. Susilowati (1997) menyatakan bahwa dengan menggunakan metode difusi sumuran dapat menghasilkan diameter zona hambat yang lebih besar. Sejalan dengan Prayoga, 2013, bahwa pada metode difusi sumuran ekstrak langsung dimasukkan ke setiap lubang maka efek untuk menghambat bakteri menjadi lebih kuat. Selain itu, tidak ada penghalang ekstrak untuk langsung berdifusi ke media agar, sehingga semua ekstrak benar-benar bekerja.
Sebelum dilakukan pengujian aktivitas antibakteri, terlebih dahulu dilakukan penghitungan koloni pada cawan petri atau yang dikenal dengan metode TPC (Total Plate Count). Perhitungan koloni ini dilakukan dengan mengencerkan 1 ml LB yang telah ditumbuhi Vibrio cholerae ke dalam 9 ml PW (Peptone Water). Kemudian dari larutan tersebut diambil 1 ml kembali dan ditambahkan 9 ml PW sehingga didapatkan pengenceran 10-2. Hal yang sama dilakukan hingga pengenceran 10-4. Setelah itu masing-masing pengenceran ditanam pada media padat TCBS dan di hitung total koloni yang muncul setelah inkubasi 24 jam. Jumlah koloni yang optimum untuk dilakukan pengujian aktivitas antibakteri adalah kisaran 30-300. Jika lebih dari 300 dinyatakan TBUD (Tidak Bisa Untuk Dihitung), jika kurang dari 30 TSUD (Terlalu Sedikit Untuk Dihitung). Penggunaan total koloni ini untuk mengetahui jumlah mikroba dominan pada petri. Sehingga pada total koloni yang digunakan pada 5 perlakuan tidak mempengaruhi besarnya zona hambat.
Total Vibrio cholerae yang digunakan pada penelitian ini adalah sebesar 1.89 x 104
CFU/ml. Zona hambat pada media NA muncul setelah penyimpanan selama 24 jam. Terbenuknya zona hambat menunjukkan bahwa ekstrak kayu secang (Caesalpinia sapan L.) memiliki senyawa bioaktif yang berperan sebagai senyawa antibakteri
sehingga mampu mengahambat pertumbuhan Vibrio cholerae. Terbentuknya zona hambat ekstrak kayu secang (Caesalpinia sappan L.) terhadap Vibrio cholerae dapat dilihat pada Gambar 3.

(c)
(a) (b)
(d)
(e)
Gambar 3. Zona hambat ekstrak kayu secang (Caesalpinia sappan L.) terhadap Vibrio cholerae. Keterangan: (a): Konsentrasi 20% (b): Konsentrasi 40% (c): Konsentrasi 60%, (d): Konsentrasi 80% (e): Konsentrasi 100%
Berdasarkan Gambar 10, zona hambat terbentuk jelas pada konsentrasi terendah 20% hingga konsentrasi tertinggi 100%. Konsentrasi yang digunakan merupakan faktor yang juga mempengaruhi besar kecilnya zona hambat yang terbentuk disekitar lubang yang telah diisi ekstrak. Semakin lebar diameter zona hambat yang terbentuk membuktikan kuatnya senyawa bioaktif itu menghambat pertumbuhan bakteri (Davis dan
Stout, 1999 dalam Djajadisastra, 2007). Menurut Davis and Stout (1971), kategori daya hambat pada diameter penghambatan dikelompokkan menjadi empat kategori, yaitu <5 mm lemah, 5-10 mm sedang 10-20 mm kuat dan > 20 mm sangat kuat. Diameter penghambatan ekstrak kayu secang (Caesalpinia sappan L.) terhadap Vibrio cholerae dengan kategori daya hambat berdasarkan David and Stout (1971) dapat dilihat pada Tabel 2.
Tabel 2. Rata-rata diameter penghambatan ekstrak kayu secang (Caesalpinia sappan L.) terhadap pertumbuhan Vibrio cholerae.
Perlakuan (Konsentrasi) |
Rataan Diameter Penghambatan (mm) |
Kategori Daya Hambat |
20% |
15,4 ± 0,2 |
Kuat |
40% |
16,9 ± 0,2 |
Kuat |
60% |
17,3 ± 0,4 |
Kuat |
80% |
20,1 ± 0,8 |
Sangat Kuat |
100% |
14,1 ± 0,8 |
Kuat |
Keterangan: ± Standar Deviasi
Berdasarkan Tabel 2 ekstrak kayu secang (Caesalpinia sappan L.) sudah mampu menghambat pertumbuhan Vibrio cholerae dari konsentrasi terendah hingga tertinggi dengan kategori kuat. Konsentrasi yang
digunakan merupakan faktor yang juga mempengaruhi besar kecilnya zona hambat yang terbentuk disekitar lubang yang telah diisi ekstrak. Semakin lebar diameter zona hambat yang terbentuk membuktikan kuatnya
senyawa bioaktif itu menghambat pertumbuhan bakteri (Davis and Stout, 1999 dalam Djajadisastra, 2007). Diameter penghambatan Vibrio cholerae terbesar diperoleh pada konsentrasi ekstrak kayu secang 80% yaitu sebesar 20.1 mm. Sedangkan diameter penghambatan terkecil diperoleh pada konsentrasi ekstrak kayu secang 100% yaitu sebesar 14.1 mm. Dilihat dari Tabel 2 diameter penghambatan terus meningkat mulai dari konsentrasi terendah 20% hingga konsentrasi 80%, tetapi menurun pada konsentrasi tertinggi 100%.
Penurunan diameter penghambatan pada konsentrasi 100% bisa terjadi karena eksrak tidak mampu berdifusi dengan baik. Menurut Maleki et al., (2008), konsentrasi ekstrak yang terlalu pekat menyebabkan ekstrak sulit berdifusi secara maksimal ke dalam medium yang mengandung inokulum. Hal ini karena konsentrasi ekstrak yang lebih tinggi dapat terjadi kejenuhan sehingga menyebabkan senyawa-senyawa aktif yang terkandung di dalam ekstrak tidak terlarut dengan sempurna. Hal ini yang menyebabkan pada konsentrasi tertinggi 100% tidak mengalami kenaikan pada diameter penghambatan.
Tingginya kandungan flavonoid pada ekstrak kayu secang (Caesalpinia sappan L.) sebesar 6,02% mempengaruhi adanya aktivitas antibakteri yang kuat. Ekstrak kayu secang (Caesalpinia sappan L.) juga mengandung antosianin sebesar 2,43%, antosianin selain sebagai antioksidan yang baik juga dapat berperan sebagai antimikroba. Faktor yang juga mempengaruhi peningkaan diameter penghambatan karena adanya konsentrasi bahan antimikroba yang meningkat setiap konsentrasi. Selain itu kemampuan aktivitas antibakteri pada ekstrak kayu secang (Caesalpinia sappan L.) ini dikarenakan kayu secang positif mengandung senyawa-senyawa metabolit sekunder lain yang berperan juga sebagai aktivitas antibakteri. Menurut Kusmiati (2014) ekstrak etanol kayu secang (Caesalpinia sappan L.)
positif mengandung flavonoid, saponin, alkaloid, tanin, fenolik, triterpenoid, steroid dan glikosida. Senyawa metabolit tersebut mampu berperan sebagai antibakteri baik pada bakteri gram negatif ataupun bakteri gram positif.
Mekanisme kerja flavonoid sebagai senyawa antibakteri dibagi menjadi 3 yaitu menghambat sintesis asam nukleat, menghambat fungsi membran sel dan menghambat metabolisme energi (Hendra, 2011 dalam Rijayanti, 2014). Dalam meghambat sintesis asam nukleat, cincin A dan B senyawa flavonoid berperan penting dalam proses interkelasi atau ikatan hydrogen yakni dengan menumpuk basa asam nukleat sehingga menghambat pembentukan DNA dan RNA. Hasil interaksi flavonoid juga akan menyebabkan kerusakan permeabilitas dinding sel Cushnie and Lamb (2005). Dalam menghambat fungsi membran sel flavonoid akan membentuk senyawa kompleks dari protein ekstraseluler dan terlarut sehingga membran sel akan rusak dan senyawa intraseluler akan keluar. Sedangkan dalam menghambat metabolism energi dengan menghambat penggunaan oksigen oleh bakteri, yaitu dengan mencegah pembentukan energi pada membrane sitoplasma dan menghambat motilitas bakteri yang berperan dalam aktivitas antimikroba dan protein ekstraseluler.
Antosianin merupakan golongan turunan dari flavonoid yang berfungsi sebagai antioksidan dan antimikroba. Menurut Cisowska et al., (2011) antosianin umumnya aktif terhadap mikroba yang berbeda. Mekanisme yang mendasari aktivitas antimikroba pada antosianin meliputi interaksi membran sel dan intraseluler dari senyawa ini. Pada E coli yang terpapar antosianin akan mengalami ketidakteraturan pada membran luar dan kebocoran sitoplasma (Cisowska et al., 2011). Bagian antosianin yang berperan sebagai animikroba adalah turunannya yaitu antosianindin dan cyanidin
3-glucoside.
Bagian yang sangat berperan pada ketahanan suatu bakteri adalah struktur dari dinding selnya karena dinding sel berfungsi sebagai pelindung dari lingkungan yang tidak aman. Selain itu membran sel bakteri berfungsi sebagai penyeleksi untuk mengatur keluar masuknya senyawa ke dalam sel bakteri. Sehingga terganggunya permeabilitas dari membran sel yang disebabkan oleh senyawa-senyawa metabolit sekunder akan merusak fungsi dari membran sel tersebut, kemudian sel akan mengalami kebocoran. Kebocoran sel ini yang menyebabkan keluarnya komponen sel. Hal ini akan mengakibatkan kerusakan pada sel bakteri tersebut dan bakteri akan menjadi lisis sehingga terjadi kematian sel bakteri.
KESIMPULAN
Ekstrak kayu secang (Caesalpinia sappan L.) memiliki total flavonoid 6,02% dan total antosianin 2,43%. Ekstrak kayu secang (Caesalpinia sappan L.) mampu menghambat pertumbuhan Vibrio cholerae pada konsentrasi 20%, 40%, 60%, 80% dan 100% dengan kategori kuat. Konsentrasi optimal untuk menghambat pertumbuhan Vibrio cholerae adalah pada konsentrasi 80% dengan diameter penghambatan 20,1 mm dengan kategori sangat kuat.
DAFTAR PUSTAKA
Abdel-Aal., El Sayed., J. Y. Christoper., and I. Rabalski. 2006. Anthocyianin Composition in Black, Blue, Pink, Purple, and Red Cereal Grain. Journal of Agricultural and Food Chemistry 54 : 4696 - 4704.
Amelia, S. 2005. Vibrio cholerae.
Departemen Mikrobiologi. Fakultas Kedokteran. Universitas Sumatera Utara. Medan.
Bermawie, N., S. Purwiyanti., Mardiana. 2008. Keragaman Sifat Morfologi hasil dan Mutu Plasma Nutfah Pegagan (Centella asiatica (L.) urban). Bul.Littro. 19(1):1-17.
Cisowska A1., D. Wojnicz., AB Hendrich. 2011. Anthocyanins as antimicrobial agents of natural plant origin. Nat Prod Commun. 6(1):149-56.
Cushnie, T. P. and Lamb, A. J. 2005. Antimicrobial activity of flavonoids, International Journal of Antimicrobial Agents, 26, 343–356.
Davis, W.W., and Stout, T.R., 1971, Disc Plate Method of Microbiological Antibiotic Assay, Appl. Microbiol., 4 (22), 666-670
Dianasari, N. 2009. Uji Efektivitas Antibakteri Ekstrak Etanol Kayu Secang (Caesalpinia sappan L.)
terhadap Staphylococcus aureus dan Shigella dysentriae Serta Bioautografinya. Skripsi. Fakultas Farmasi. Universitas Muhammadiyah Surakarta. Surakarta.
Djajadisastra, A.N. 2007. Penapisan
Komponen Antibakteri dan Uji
Toksisitas dari Spons Perairan Taka Bonerate Sulawesi Selatan. Skripsi. Bogor. Program Studi Teknologi Hasil Perikanan Fakultas Perikanan dan Ilmu Kelautan Universitas Institut Pertanian Bogor.
Kharirie. 2013. Diagnosa Vibrio cholerae dengan Metode Kultur dan Polimerase Chain Reaction (PCR) pada Sampel Sumber Air Minum. Jurnal Biotek Medisiana Indonesia. Vol:2(2): Hal:51-58.
Kimestri, A.B., Indratiningsih and Widodo.
2018. Microbiological and physicochemical quality of pasteurized milk supplemented with sappan wood extract (Caesalpinia sappan L.). International Food Research Journal 25(1): 392-398.
Koirewoa, Y.A., Fatimawali, dan W. I. Wiyono. 2012. Isolasi dan Identifikasi Senyawa Flavonoid dalm Daun Beluntas. Universitas Sam Ratulangi. Manado. Kusmiati., Dameria., D. Priadi. 2014. Analisa Senyawa Aktif Ekstrak Kayu Secang (Caesalpinia sappan L.) Yang Berpotensi Sebagai Antimikroba. Seminar Nasional Teknologi Industri Hijau.
Lefevre M., L. Howard., M. Most., Z. Ju., J. Delany.
Maleki., et al. 2008. Antibacterial Activity of The Fluid of Iranian Torilis Leptophylla Against Some Clinical Pathogen. Pakistan Journal of Biologycal Science. 11, (9), 1286-1289.
Misna., and D. Khusnul. 2016. Aktivias Antibakteri Ekstrak Kulit Bawang Merah (Allium cepa L.) Terhadap Bakteri Staphylococcus aureus. Galenika Journal of Pharmacy. Vol. 2 (2): 138 – 144.
Moein S., and R.M. Mahmood. 2010. Relationship between antioxidant properties and phenolics in Zhumeria majdae. Journal of Medicinal Plants Research (7): 517-521.Santoso, U. 2006. Antioksidan. Sekolah Pasca Sarjana Universitas Gadjah Mada, Yogyakarta.
Nollet, Leo, M. L., 2004, Handbook of Food Analysis, Second Edition, 1513, 15231529, Marcel Dekker, Ink., New York.
Panovska T K., S. Kulevanova., and Stefova. 2005. In Vitro Antioxidant Activity of Some Teucrium Spesies (Lamiaceae). Acta Pharm.
Prayoga, D. 2013. Perbandingan Efek Ekstrak Daun Sirih Hijau (Piper betle L.) dengan Metode Difusi Disk dan Sumuran Terhadap Pertumbuhan Bakteri Staphylococcus aureus. Skripsi Program Studi Pendidikan Dokter Fakultas Kedokteran dan Ilmu Kesehatan Universitas Islam Negeri Syarif Hidayatullah. Jakarta
Rijayanti, R. K., 2014, Uji Aktivitas Antibakteri Ekstrak Etanol Daun Mangga Bacang (Mangifera foetida L.) terhadap Staphylococcus aureus Secara In Vitro, Naskah Publikasi, Program Studi Pendidikan Dokter, Fakultas Kedokteran Universitas Tanjungpura
Rusita, Youstiana Dwi and Suhartono. 2016. Flavonoids content in extracts secang (Caesalpinia sappan L.) maceration method infundation analysis and visible ultraviolet spectrophotometer.
International Journal of Medical Research & Health Sciences.
Vol.4:176-181.
Santoso, U. 2006. Antioksidan. Yogyakarta: Sekolah Pasca Sarjana Unversitas Gadjah Mada.
Selawa, W., Runtuwene, M.R.J., Citraningtyas, G. 2013. Kandungan Flavonoid dan Kapasitas Antioksidan Total Ekstrak Etanol Daun Binahong (Anredera cordifolia (Ten.) Steenis, Jurnal Ilmiah Farmasi Pharmacon. Universitas Sam Ratulangi.
Sudarmadji, S., B. Haryono., Suhardi. 1997. Prosedur Analisis Untuk Bahan
Makanan dan Pertanian. Liberty:
Yogyakarta.
Sudarsono, D. Gunawan, S. Wahyuono, I.A. Donatus., Purnomo. 2002. Tumbuhan Obat II, Hasil Penelitian, Sifat-Sifat, dan Penggunaan. Yogyakarta: Pusat Studi Obat Tradisional UGM.
Sumarni, 1994, Uji Daya Antibakteri Fraksi Petroleum Eter Fraksi Kloroform, dan Fraksi Metanol Kayu Secang (Caesalpinia sappan L.) Terhadap Staphylococcus aureus dan Escherichia coli serta Profil
Widowati, Wahyu. 2011. Uji Fitokimia dan Potensi Antioksidan Ekstrak Etanol Kayu Secang (Caesalpinia sappan L.). Universitas Kristen Maranatha. Vol. 11:23-31.
Widyastana, I Wayan Yogi. 2015.
Keberadaan Bakteri Patogen Vibrio
cholerae Pada Beberapa Hasil
Perikanan Yang Dijual Di Pasar Tradisional Kota Denpasar. Tesis.
Program Magister. Program Studi Biologi. Program Pasca Sarjana. Universitas Udayana. Denpasar.
Suzery, M., S. Lestari., and B. Cahyono. 2010. Penentuan Total Antosianin dari Kelopak Bunga Rosela (Hibiscus sabdariffa L.) dengan Metode Maserasi dan Sokhletasi. Jurnal Sains & Matematika Vol.18(1):1-6.
Xu, B.J., and Chang, S.K.C. 2007. A comparative study on phenolic profiles and antioxidant activities of legumes affected by extraction solvent. Journal of Food Science 72: 59-6
225
Discussion and feedback